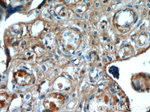
AMOT Antibody in Immunohistochemistry (Paraffin) (IHC (P))

Search
Proteintech
AMOT Monoclonal Antibody (3H7B3)
{{$productOrderCtrl.translations['antibody.pdp.commerceCard.promotion.promotions']}}
{{$productOrderCtrl.translations['antibody.pdp.commerceCard.promotion.viewpromo']}}
{{$productOrderCtrl.translations['antibody.pdp.commerceCard.promotion.promocode']}}: {{promo.promoCode}} {{promo.promoTitle}} {{promo.promoDescription}}. {{$productOrderCtrl.translations['antibody.pdp.commerceCard.promotion.learnmore']}}
产品信息
60156-1-IG
种属反应
宿主/亚型
分类
类型
克隆号
抗原
偶联物
形式
浓度
纯化类型
保存液
内含物
保存条件
运输条件
产品详细信息
This antibody only recognizes p130.
靶标信息
AMOT (Angiomotin) belongs to the motin family of angiostatin binding proteins characterized by conserved coiled-coil domains and C-terminal PDZ binding motifs. AMOT plays a central role in tight junction maintenance via the complex formed with ARHGAP17 - which acts by regulating the uptake of polarity proteins at tight junctions. AMOT is expressed predominantly in endothelial cells of capillaries as well as larger vessels of the placenta where it may mediate the inhibitory effect of angiostatin on tube formation and the migration of endothelial cells toward growth factors during the formation of new blood vessels.
仅用于科研。不用于诊断过程。未经明确授权不得转售。
篇参考文献 (0)
生物信息学
蛋白别名: Angiomotin; angiomotin p130 isoform; angiomotin p80 isoform
基因别名: AMOT; KIAA1071
UniProt ID: (Human) Q4VCS5
Entrez Gene ID: (Pig) 100158213, (Human) 154796